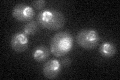
YMR219W
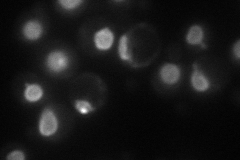
YMR219W
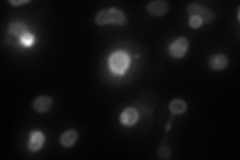
YMR219W
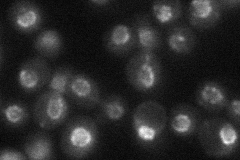
YMR219W
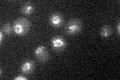
YMR219W

View description
Protein localized to the nuclear periphery, involved in telomeric silencing; interacts with PAD4-domain of Sir4p
Localization:
Intensity:
Fold change:
Significance:
-
C’ GFP library in SD
nuclear periphery24.78 -
N' NOP1pr-GFP in SD
punctate,nuclear periphery71.9305 -
N' TEF2pr-mCherry in SD
punctate,nuclear periphery54.7098 -
N' NATIVEpr-GFP in SD
punctate,nuclear periphery36.2645 -
N' TEF2pr-VC and Cyto-VN in SD

nuclear periphery29.5202 -
C’ GFP library in SD+DTT

nuclear periphery27.481.1No -
C’ GFP library in SD+H2O2

nuclear periphery26.561.07No -
C’ GFP library in Starvation Media
nuclear periphery21.720.87No -
C’ GFP library on the background of Pup2-DaMP

nuclear periphery -
C’ GFP library on the background of CCT mutant

nuclear periphery28.80081.16219No
